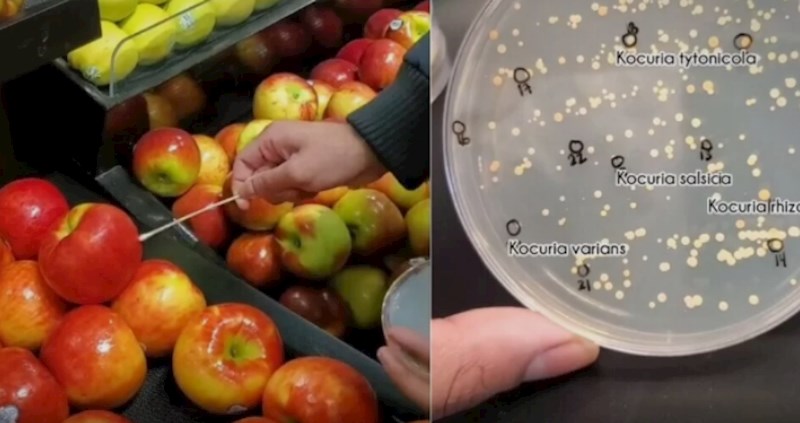
Viralni video: Biolog testirao koje se sve bakterije nalaze na hrani koju kupujemo svakog dana

Razno
• 12 srpnja 2022
Viralni video: Biolog testirao koje se sve bakterije nalaze na hrani koju kupujemo svakog dana
4K
Okej, nakon dolaska iz trgovine obavezno pranje ruku i hrane!
















